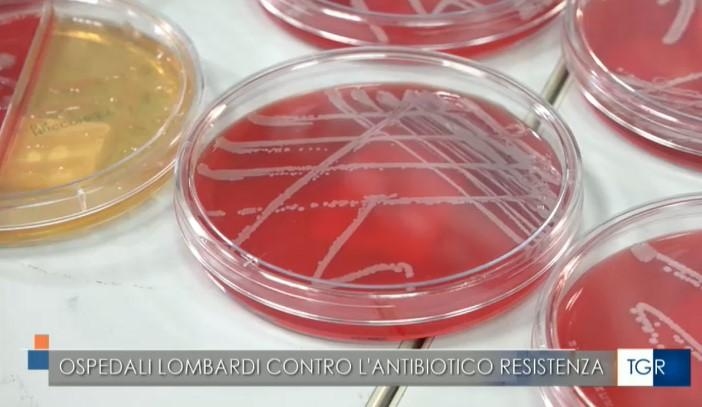
notizia

#RASSEGNASTAMPA Antibiotico-resistenza in corsia: Policlinico di Milano capofila di un grande studio su 18 ospedali lombardi
— di Redazione
Lo sviluppo di batteri resistenti ai farmaci è un fenomeno allarmante a livello globale. Anche in ambito ospedaliero è in corso da tempo un importante sforzo per contrastare l'antibiotico-resistenza, ovvero la capacità di questi microrganismi di sopravvivere all'azione degli agenti antimicrobici. Il Policlinico di Milano è capofila di uno studio sugli effetti di un programma di Antimicrobial stewardship che ha coinvolto 18 strutture ospedaliere pubbliche e private della Regione Lombardia per migliorare la prescrizione dei farmaci antibiotici e contrastare la diffusione dell’antibiotico-resistenza.
Nel nostro Paese, i tassi di antibiotico-resistenza restano elevati in modo preoccupante. Anche il contesto clinico contribuisce al problema, poiché l’impiego frequente di antibiotici — in particolare quelli ad ampio spettro — favorisce la selezione e la diffusione di ceppi batterici resistenti. Quanto meno appropriata è la prescrizione di questi farmaci in ambito ospedaliero, tanto maggiore è il rischio che si selezionino batteri resistenti e che questi provochino infezione nei pazienti fragili.
Il Policlinico di Milano ha partecipato a un Progetto di Ricerca Finalizzata di Rete che che prevedeva il coinvolgimento delle Regioni Lazio, Emilia-Romagna e Lombardia, coordinando l’unità di Progetto della nostra Regione, che ha coinvolto 18 ospedali. Obiettivo dello studio era di valutare l’impatto dell’implementazione di un programma di antimicrobial stewardship in queste strutture, ovvero capire in che misura sia possibile migliorare l’appropriatezza dell’uso della terapia antibiotica attraverso interventi mirati di formazione e monitoraggio delle prescrizioni antibiotiche rivolti ai professionisti sanitari.
Guarda il servizio del TGR Lombardia con l'intervista alla prof.ssa Alessandra Bandera, Direttore delle Malattie Infettive del Policlinico di Milano e alla prof.ssa Annapaola Callegaro, Direttore di Microbiologia e Virologia del Policlinico di Milano.
Guarda il Servizio del TGR Lombardia (dal minuto 11.15)
Uso consapevole degli antibiotici
18 novembre – Giornata Europea degli Antibiotici
18–24 novembre – Settimana Mondiale della Consapevolezza sugli Antibiotici





 News e consigli dagli esperti
News e consigli dagli esperti